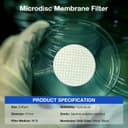
Thumbnail 3

🔬 Elevate your microbial monitoring game with precision and ease!
The SimPure 100 X MCE Gridded Membrane Filter is a sterile, hydrophilic 47mm membrane with a 0.45μm pore size, designed for environmental monitoring and microbial detection. Its gridded surface facilitates accurate colony counting, while aseptic packaging ensures contamination-free use. Certified by ISO9001 and FDA, it delivers reliable lab-grade filtration performance.






| ASIN | B07DK85P6S |
| Item model number | FMCE047045GWS-100P |
| Manufacturer | SimPure |
| Package Dimensions | 8.89 x 8.25 x 4.44 cm; 113 g |
G**N
They are as described and same as pictured.
A**D
Wanted to filter undissolved/suspended fluorescein dye from water. Completely failed filtering because it just didn't allow and water flow through it.
B**Y
Functional. Though Much smaller than expected, not adhesive they did work. And customer service was great
G**A
I can make them work in a 56 mm funnel but to big for universal 47mm, another star off for little information provided on compatibility only really recommend these for biological application.
H**R
Used for water testing & worked well
Trustpilot
Hace 4 días
Hace 1 semana